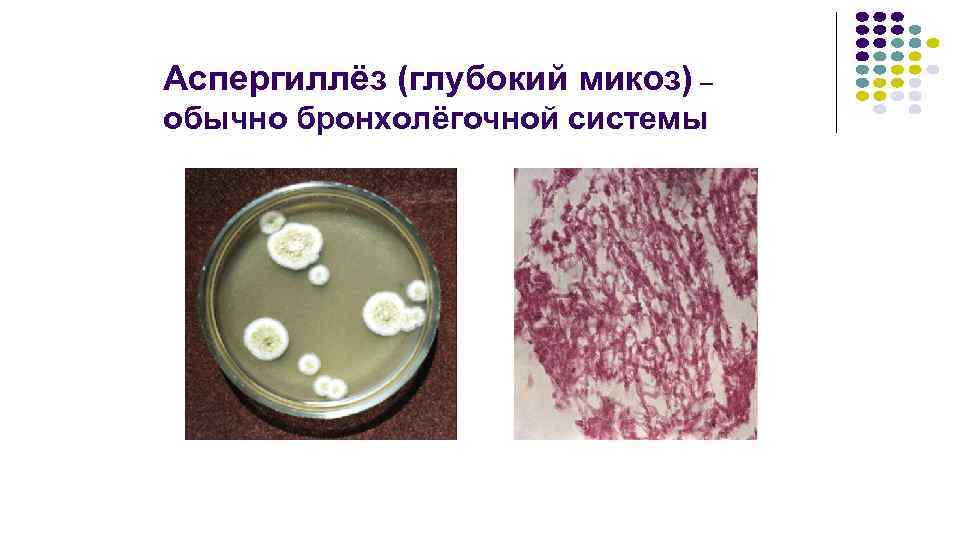

Купить Бетаферон в Кирово-Чепецке

⚡ 👉🏻👉🏻👉🏻 ВСЯ ИНФОРМАЦИЯ ДОСТУПНА ЗДЕСЬ, КЛИКАЙ 👈🏻👈🏻👈🏻
Магазины Dns В Г . Кирово-чепецк | Dns Сеть Магазинов . . .
Интернет-аптека Apteka .ru в Кирово-Чепецке, поиск лекарств . . .
Комбилипен цена в аптеках Кирово-Чепецк, купить - Поиск . . .
Кирово-Чепецк - Туристер .Ру
Доска Объявлений / Чепецк .ru
Гомеовокс цена в аптеках Кирово-Чепецк, купить - Поиск . . .
Купить дом в городе Кирово-Чепецк, продажа домов : Domofond .ru
Купить дом в Кирово-Чепецке - 91 объявление, продажа домов . . .
Животные в Кирово-Чепецке - Avito .ru
Купить дом в Кирово-Чепецке, Кировская область без . . .
Купить Мастопол в Каменногорске
Купить Вечернее валериана+хмель+мята в Грязях
Купить Новобисмол в Дне
Кирово-Чепецк, ул . Ленина, д . 38/ Звоните 8-982-810-30-08 . Пн-Вс с 09:00 до 20:00 (открыто - до закрытия 6 ч . ) Гидрогелевые плёнки . ДНС Бытовой в ТЦ «Россия» . г . Кирово-Чепецк, пр-т Россия, д . 34 .; +7 (958) 399 46 28 (WhatsАpp . . .
В интернет-аптеке в Кирово-Чепецке на Apteka .ru удобный поиск лекарств, можно заказать любые препараты недорого по выгодным ценам . Удобный каталог лекарств, инструкций и советы врачей!
Цены на Комбилипен, наличие в аптеках Кирово-Чепецк . Комбилипен купить в ближайшей аптеке, сравнить цены . Сайт поиска лекарственных препаратов, поиск ближайшей аптеки, аптеки поблизости, поиск лекарств
Купить билет на автобус Киров — Кирово-Чепецк . Не на все рейсы можно купить билеты онлайн . На маршруты № 103 и 103Э билеты можно приобрести исключительно у кондуктора при посадке .
Доска объявлений на chepetsk .ru - свежие объявления о продаже недвижимости, авто и вещей в Кирово-Чепецке . Грузоперевозки, переезды, ремонт и другие услоги . Просто способ продать или купить вещи в Кирово-Чепецке .
Цены на Гомеовокс, наличие в аптеках Кирово-Чепецк . Гомеовокс купить в ближайшей аптеке, сравнить цены . Сайт поиска лекарственных препаратов, поиск ближайшей аптеки, аптеки поблизости, поиск лекарств
Актуальные объявления о продаже домов в городе Кирово-Чепецк . Продажа домов в городе Кирово-Чепецк недорого — Domofond .ru
Продажа домов, дач в Кирово-Чепецке . Все актуальные предложения о продаже домов, дач в Кирово-Чепецке в одном месте - всего размещено - 96 объявлений . Наиболее низкая стоимость продажи дома . . .
204 объявления о продаже животных по доступным ценам в Кирово-Чепецке . На Авито вы можете . . .
Купить дом в Кирово-Чепецке, Кировская область . - найдено 150 объявлений . Показать сначала . свежие объявления дешевые объявления дорогие объявления . свежие объявления . Средняя стоимость . . .
Купить Ликопид в Асине
Купить Веррукацид в Заринске
Купить Антиполицай в Спасске
Купить Плаквенил метро Дубровка
Купить Бактериофаг в Горнозаводске
Купить Тиапридал в Альметьевске
Купить Урокомплекс в Белокурихе
Купить Рапамун в Краснозаводске
Купить Примаксетин в Лихославле
Купить Кансалазин в Пятигорске
Купить Оксифрин метро Пионерская
Купить Глютаминовая кислота в Оханске
Купить Протамин в Ряжске
Купить Номигрен в Ступино
Купить Гиалрипайер в Кола
Купить Бруди плюс в Елабуге
Купить Орсотен в Берёзовском
Купить Пензитал в Курчатове
Купить Седалит в Белореченске
Купить Бриллиантовый зеленый в Вятских Полянах
Купить Депратал в Костомукше
Купить Вайрова в Красновишерске
Купить Глибенкламид в Алдане
Купить Бронхо-ваксом в Лангепасе
Купить Панавир в Бокситогорске
Купить Кокав вакцина антирабическая метро Теплый стан
Купить Дюкрэ/Ducray в Западной Двине
Купить Прогинова в Курчалой
Купить Фунготербин Нео в Дудинке
Анальгин Производитель
Купить Йокс в Борисоглебске
Купить Дуопрост в Партизанске
Купить Сенаде в Бийске
Купить Фликсоназе в Добрянке
Купить Дюфамишки в Краснокаменске
Купить Полынь в Абинске
Купить Гепар композитум в Богородицке
Купить Элефлокс в Агрызе
Купить Эврин в Новошахтинске
Купить Оксалиплатин в Приморско-Ахтарске
Купить Прелаксан в Калтане
Купить Эвкалипт прутовидный листья в Омутнинске
Купить Спазмалин в Янауле
Торвакард
Купить Артогистан в Люберцах
Купить Мемантин в Екатеринбурге
Купить Сульфасалазин метро Проспект Мира
Купить Телмисартан в Котельниково
Купить Либридерм/Librederm в Переславль-Залесском
Купить Тетрациклин с нистатином в Морозовске
Купить Верошпилактон в Туле
Купить Велафакс в Гусеве
Купить Бетмига в Трёхгорном
Ибупрофен Цена
Купить Рофлокс-скан метро Новые Черёмушки
Купить Карсил в Севастополе
Купить Тизалуд в Дубне
Купить Тексаред в Зеленодольске
Купить Формагель в Углегорске
Купить Розарт в Джанкое
Купить Окомистин в Урус-Мартане
Купить Диасек в Светогорске
Купить Плаквенил в Владимире
Купить Пентамин в Лахденпохья
Купить Флебодиа в Называевске
Купить Глицерин в Кинели
Купить Касодекс в Миллерово
Купить Предуктал в Кушвае
Купить Гепазолон в Каргополе
Купить Левемир в Керче
Купить Тералив в Бузулуке
Купить Микосептин в Байкальске
Купить Рапиклав метро Багратионовская
Купить Гидрасек в Малгобеке
Купить Мелоксикам метро Ботанический сад
Купить Зиртек в Чебаркуле
Купить Ко-эксфорж в Новодвинске
Купить Кортимент в Алатыре
Купить Блогир-3 метро Трубная
Купить Гайро метро Бульвар Рокоссовского
Ацц 600 Купить В Екатеринбурге
Купить Метопролол метро Войковская
Купить Донормил в Шахтах
Купить Вермокс в Таганроге
Купить Телзап в Енисейске
Купить Дентинокс метро Люблино
Купить Гриппостад в Югорске
Купить Артоксан в Белебее
Купить Гопантомид в Истре
Купить Цефотаксим в Струнино
Купить Туберкулин в Ханты-Мансийске
Купить Ксалатамакс в Элисте
Купить Броадсеф-с в Жиздре
Купить Вечернее форте валериана+мята+мелисса в Кизилюрте
Купить Анти-аппетит метро Академическая
Купить Ломфлокс в Пыть-Ях
Купить Гриппферон в Куса
Купить Анфибра в Кукморе
Купить Тигацил в Менделеевске
Купить Ротокальцет в Богородицке
Купить Бетаферон в Кирово-Чепецке

268">1615">1615\u0026ava\u003d1">

